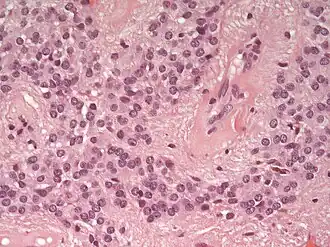

Ependimoma
| Ependimoma | ||
|---|---|---|
![]() | ||
| Especialidad | oncología | |
Un ependimoma es una neoplasia intracraneal del sistema nervioso central , que aparecen comúnmente en el cuarto ventrículo en niños y en el conducto ependimario o raquídeo en la región lumbosacra en adultos. Los enfermos afectos de neurofibromatosis tipo II pueden desarrollar este tipo de neoplasia. Los ependimomas se tratan quirúrgicamente mediante una resección total, presentando un pronóstico bueno en cuanto a supervivencia. A los 5 años se espera una sobrevida de 80%, aunque no todos los ependimomas puede resecarse completamente, por lo que se emplea además la radioterapia y quimioterapia.[1][2]
Morfología
Los ependimomas se componen de células con núcleos regulares y ovoides o circulares. Por lo general se acompañan de una parénquima denso y fibroso haciendo que las células tumorales adopten una forma glandular y elongada que tienen cierto parecido al canal ependimal embriológico con vasos sanguíneos irrigando la neoplasia.[3] Los ependimomas extraespinales o extradurales pueden ser una forma muy inusual de teratoma.[4][5]
Epidemiología
Los ependimomas constituyen cerca del 5% de los gliomas intracraneales de los adultos y un 10% de los tumores del sistema nervioso central en niños. Su incidencia presenta dos picos, uno alrededor de los 5 años de edad, y otro a los 35 años. En la infancia aparecen en los ventrículos especialmente el cuarto ventrículo y en los adultos aparecen en el canal que contiene a la médula espinal.[1]
Cuadro clínico
Cuando se instalan en el cerebro, pueden producir dolor de cabeza, náuseas y vómitos al obstruir el flujo del líquido cefalorraquídeo. La obstrucción puede también causar hidrocefalia. Otros síntomas incluyen la pérdida del apetito, dificultad para dormir, pérdida temporal de distinguir colores, y de la memoria, entre otros. Tras una intervención quirúrgica puede quedar diplopía como secuela.[cita requerida]
Referencias
- ↑ a b Harrison Principios de Medicina Interna 16a edición (2006). «Tumores cerebrales primarios». Harrison online en español. McGraw-Hill. Archivado desde el original el 27 de octubre de 2008. Consultado el 17 de julio de 2008.
- ↑ «Search results for: ependymoma». MSD Manual Professional Edition (en inglés británico). Consultado el 24 de febrero de 2024.
- ↑ Kumar, et al. (2005). The Central Nervous System. Pathologic Basis of Disease. 7th Edition. Philadelphia: Elsevier Saunders.
- ↑ Aktuğ T, Hakgüder G, Sarioğlu S, Akgür FM, Olguner M, Pabuçcuoğlu U. (2000) Sacrococcygeal extraspinal ependymomas: the role of coccygectomy. J Pediatr Surg. 35(3):515-518. PubMed
- ↑ Hany MA, Bouvier R, Ranchère D, Bergeron C, Schell M, Chappuis JP, Philip T, Frappaz D (1998). «Case report: a preterm infant with an extradural myxopapillary ependymoma component of a teratoma and high levels of alpha-fetoprotein». Pediatric hematology and oncology 15 (5): 437-41. PMID 9783311.
Enlaces externos
- En Epistemoikos hay más información sobre Ependimoma.
- Revisiones sistemáticas en Epistemoikos sobre Ependimoma